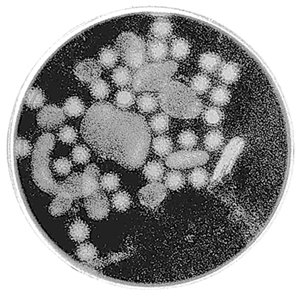
겨울 식중독 원인인 노로바이러스.

공유하기
겨울 식중독 더 위험해요
-
입력 2007년 12월 3일 03시 03분
글자크기 설정
실내활동 많아 전염 더 잘돼
식중독이 여름철에만 발생하는 것으로 생각하면 큰 오산이다. 겨울철 식중독이 더 위험하다.
여름철에 발생하는 세균성 식중독과 달리 겨울 식중독은 노로바이러스에 의한 것이 대부분으로 전염성이 강한 것이 특징이다.
식품의약품안전청이 2006년 식중독 실태를 조사한 결과 연간 259건 중 50건(19.3%)이 12월, 1월, 2월 3개월에 집중됐다.
이 가운데 노로바이러스에 의한 식중독이 25건으로 절반이었다. 올해 1, 2월 발생한 59건의 식중독 중에도 노로바이러스에 의한 것이 25건(42.3%)이었다.
겨울철에 노로바이러스 식중독이 많은 것은 바이러스성 식중독균이 세균성 식중독균보다 낮은 온도에서 더 잘 살아남기 때문이다.
또 겨울에는 개인 위생관리가 소홀해지고 실내 활동이 많아지기 때문에 식중독에 걸린 사람에게서 다른 사람으로 전염되기 쉽다.
세균성 식중독은 오염된 음식을 먹은 사람에게서만 일어나지만 노로바이러스에 의한 식중독은 감염된 사람의 구토물, 변 등에 의해 간접적으로 다른 사람에게 전파된다. 겨울철 식중독에 걸린 사람의 배설물이 있는 곳은 염소계 소독제(락스)를 이용해 빨리 세척해야 노로바이러스 확산을 방지할 수 있다.
음식은 섭씨 85도 이상에서 1분 이상 가열해 먹어야 안전하다. 춥다고 손 씻기를 게을리 해선 안 된다. 노로바이러스 식중독에 걸렸던 사람은 다 나았다고 하더라도 사흘 정도 음식 만드는 일은 피하도록 한다.
식중독 환자는 일단 한두 끼는 굶고 이온음료나 설탕을 넣은 음료를 섭취해 수분과 칼로리를 보충하도록 한다.
설사가 나더라도 지사제를 함부로 먹으면 안 된다. 장 안에 남아 있는 균이 다 배출돼야 식중독이 낫는데 지사제를 쓰면 오히려 식중독균 배출을 막기 때문이다.
김현지 기자 nuk@donga.com
성매매 특별법 시행 논란 : 각계 표정-주한미군 >
-

오늘과 내일
구독
-

허명현의 클래식이 뭐라고
구독
-

고양이 눈
구독
트렌드뉴스
-
1
최민희 의원, ‘재명이네 마을’서 영구 강퇴 당했다
-
2
[단독]“거부도 못해” 요양병원 ‘콧줄 환자’ 8만명
-
3
“합격, 연봉1억2000만원” 4분 뒤 “채용 취소합니다”…法, 부당 해고 판결
-
4
나라 곳간지기에 與 4선 박홍근… ‘비명횡사’ 박용진 총리급 위촉
-
5
‘알바는 퇴직금 없다’는 거짓말… 1년간 주 15시간 근무 땐 보장
-
6
드론 수백대 줄지어…이란, 무기 터널 공개 ‘전쟁 능력’ 과시
-
7
“장동혁 서문시장 동선 따라 걸은 한동훈…‘압도한다’ 보여주려”[정치를 부탁해]
-
8
英기지 내어주고 佛해군 파견…‘이란 공습’에 유럽 가세
-
9
하메네이 제거하고 중국 오는 트럼프…시진핑 웃을 수 있나
-
10
[단독]靑 “김민기” vs 대법 “박순영”… 이번엔 대법관 인선 놓고 평행선
-
1
최민희 의원, ‘재명이네 마을’서 영구 강퇴 당했다
-
2
드론 수백대 줄지어…이란, 무기 터널 공개 ‘전쟁 능력’ 과시
-
3
기획예산처 장관 박홍근 지명…‘이화영 변호인’ 정일연, 권익위원장
-
4
트럼프, 하메네이 제거… 더 거칠어진 ‘힘의 질서’
-
5
‘까불면 다친다’ 또 목격한 김정은… 核보유 더 집착 가능성
-
6
李 “집 팔기 싫다면 두라, 이익-손실 정부가 정해”
-
7
[김승련 칼럼]장동혁-한동훈, 알고 보면 운명공동체
-
8
순방 가서도 ‘부동산’…李 “韓 집값 걱정? 고민 않도록 하겠다”
-
9
“日 국민 대부분은 韓에 ‘과거사’ 사과 당연하다고 생각”
-
10
[사설]‘사법개혁 3법’ 통과… 법집행자들의 良識으로 부작용 줄여야
트렌드뉴스
-
1
최민희 의원, ‘재명이네 마을’서 영구 강퇴 당했다
-
2
[단독]“거부도 못해” 요양병원 ‘콧줄 환자’ 8만명
-
3
“합격, 연봉1억2000만원” 4분 뒤 “채용 취소합니다”…法, 부당 해고 판결
-
4
나라 곳간지기에 與 4선 박홍근… ‘비명횡사’ 박용진 총리급 위촉
-
5
‘알바는 퇴직금 없다’는 거짓말… 1년간 주 15시간 근무 땐 보장
-
6
드론 수백대 줄지어…이란, 무기 터널 공개 ‘전쟁 능력’ 과시
-
7
“장동혁 서문시장 동선 따라 걸은 한동훈…‘압도한다’ 보여주려”[정치를 부탁해]
-
8
英기지 내어주고 佛해군 파견…‘이란 공습’에 유럽 가세
-
9
하메네이 제거하고 중국 오는 트럼프…시진핑 웃을 수 있나
-
10
[단독]靑 “김민기” vs 대법 “박순영”… 이번엔 대법관 인선 놓고 평행선
-
1
최민희 의원, ‘재명이네 마을’서 영구 강퇴 당했다
-
2
드론 수백대 줄지어…이란, 무기 터널 공개 ‘전쟁 능력’ 과시
-
3
기획예산처 장관 박홍근 지명…‘이화영 변호인’ 정일연, 권익위원장
-
4
트럼프, 하메네이 제거… 더 거칠어진 ‘힘의 질서’
-
5
‘까불면 다친다’ 또 목격한 김정은… 核보유 더 집착 가능성
-
6
李 “집 팔기 싫다면 두라, 이익-손실 정부가 정해”
-
7
[김승련 칼럼]장동혁-한동훈, 알고 보면 운명공동체
-
8
순방 가서도 ‘부동산’…李 “韓 집값 걱정? 고민 않도록 하겠다”
-
9
“日 국민 대부분은 韓에 ‘과거사’ 사과 당연하다고 생각”
-
10
[사설]‘사법개혁 3법’ 통과… 법집행자들의 良識으로 부작용 줄여야
-
- 좋아요
- 0개
-
- 슬퍼요
- 0개
-
- 화나요
- 0개




댓글 0